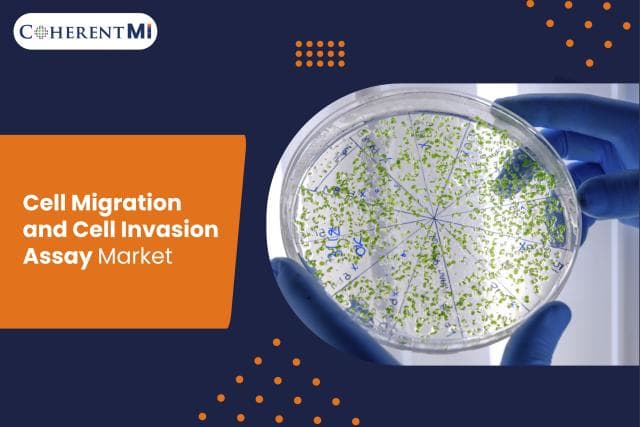
1731046350.jpg

Cell migration and invasion are crucial processes in various physiological and pathological conditions including embryonic development, wound healing, angiogenesis, tumor metastasis, and inflammation. Over the past few decades, there have been significant advancements in our understanding of the molecular mechanisms that control cell migration and invasion. Various in vitro assays have been developed to study these complex processes at the cellular and molecular level which are playing an important role in drug discovery and development efforts.
Types of Cell Migration and Invasion Assays
There are different types of assays used to study cell migration and invasion depending on the specific research question:
Wound Healing Assay
One of the most common and simple assays to study cell migration is the wound healing or scratch assay. In this assay, a gap or wound is created on a monolayer of adherent cells using a pipette tip or sterile scraper. Cells are then allowed to migrate into the gap and closure of the wound is monitored over time using a microscope connected to a camera. Parameters like wound closure rate and percentage wound closure can provide important insights into factors influencing cell migration.
Chemotaxis/Chemokinesis Assay
These assays study directed or random cell migration in response to a chemical gradient. In chemotaxis assays, concentration gradients of chemoattractants are generated usingBoyden chambers, ibidimigration inserts or microfluidic devices. Cells migrate either towards an increasing or decreasing gradient of chemicals. Chemokinesis assays measure random cell migration in response to uniform chemical concentrations.
Spheroid Invasion Assay
Three-dimensional spheroid invasion assays are commonly used to study invasion of tumor cells into the surrounding extracellular matrix (ECM). Spheroids of tumor cells are typically embedded in ECM proteins like collagen or Matrigel. Invasion of tumor cells out of the spheroid core into the surrounding matrix is then observed over time. Parameters like number of invading cells, invasion depth and area help analyze tumor cell invasiveness.
Cell Invasion Chamber Assay
Cell invasion chambers like Boyden chambers, Transwell inserts or Snapwells consist of an upper and lower chamber separated by a porous membrane coated with ECM proteins. Cells are seeded onto the upper side of the membrane and chemoattractants are added to the lower chamber. Cells that migrate and invade through the ECM-coated membrane into the lower chamber are quantified after a stipulated time period.
Live Cell Imaging Assays
Advanced live cell imaging techniques using time-lapse fluorescent or phase contrast microscopy enable real-time visualization and tracking of single cells or cohorts of migrating and invading cells. Parameters like migration track, distance, velocity, persistence etc. can be measured over multiple time points providing dynamic information about motility patterns.
Key Growth Drivers
The global cell migration and cell invasion assay is witnessing significant growth due to various factors:
Increasing Cancer Incidence and Emphasis on Metastasis Research
Cell migration and invasion play a crucial role in tumor metastasis, which is the major cause of cancer mortality. Understanding the molecular mechanisms of metastasis and identifying targets to inhibit it is a key focus area in cancer research. This is positively impacting the demand for various cell-based assays to study tumor cell motility and invasion.
Growth in Pharmaceutical R&D Spending
Pharmaceutical and biotechnology companies are investing heavily in drug discovery and development programs targeting cancer, fibrosis, inflammation and other diseases where cell migration plays a pathogenic role. This is generating greater uptake of cell migration and invasion assays for cell-based screening, target validation and downstream development activities.
Technological Advancements
Manufacturers are continuously advancing assay platforms by incorporating imaging, microfluidics and other technologies to develop high-throughput, quantitative and physiologically relevant assays. The availability of live-cell imaging systems, 3D cell cultures, microfluidic-based chemotaxis chips and other novel technologies is augmenting growth.
Increased Outsourcing of Preclinical Research
Rise in outsourcing of preclinical research activities to contract research organizations (CROs) and academic research institutes is creating additional demand for cell migration and invasion assays from commercial suppliers. This factor is expected to significantly influence the marketplace.
Regional Insights
North America accounts for the largest share of the cell migration and invasion assay owing to extensive R&D investments, presence of leading pharmaceutical companies, growing biotechnology industry and availability of state-of-the-art research infrastructure in the region.
On the other hand, Asia Pacific is predicted to witness the fastest growth during the forecast period. This can be attributed to rising research funding, increasing healthcare expenditure, establishment of new pharmaceutical units by global companies and economic development in major Asian countries. India and China represent highly lucrative for cell migration assay providers due to a low-cost manufacturing environment and presence of skilled scientific workforce.Some of the prominent players operating in the cell migration and invasion assay include Merck KGaA, Thermo Fisher Scientific, Cell Biolabs, Inc., Bio-Techne, Essen BioScience, Inc., Insphero, Merck KGaA, BD, and QGel SA. Players are focusing on new product launches, collaborations and mergers to augment their portfolio of assay kits and platforms for cell-based migration and invasion studies.In summary, cell migration and invasion are critical biological processes influencing various physiological and pathological conditions. Understanding the molecular mechanisms governing cell motility is crucial for advancing drug discovery efforts targeting cancer, fibrosis, infection and inflammation. The development of innovative, quantitative and high-throughput cell-based assays is thus catalyzing research activities. Significant developments in technologies and techniques are further fueling growth of the cell migration and invasion assay.